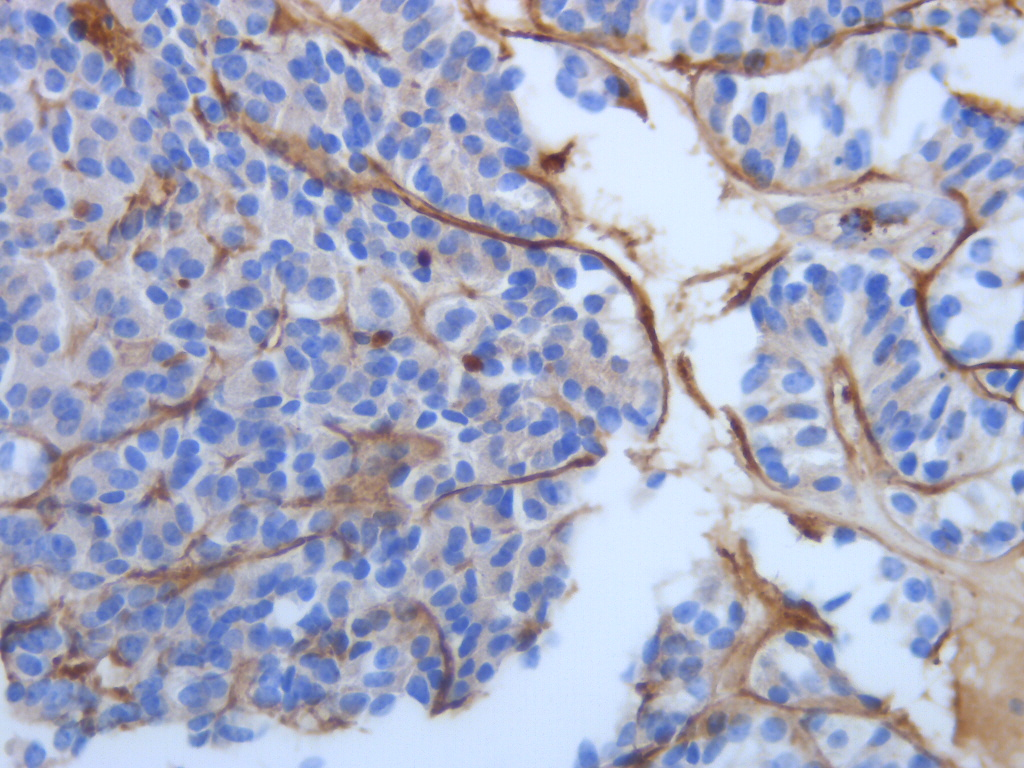

Laboratorio de anatomía patológica
Estamos enfocados en el análisis eficiente de cada muestra en nuestras manos, entendemos que cada uno representa la vida de nuestro paciente y por eso nos enfocamos en la eficiencia, trazabilidad y diagnósticos precisos.